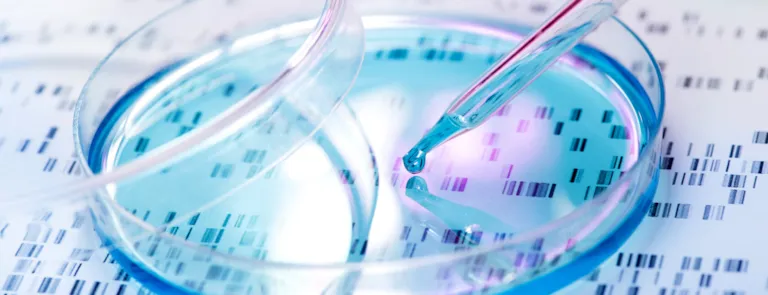
DNA sample being pipetted into petri dish with DNA scheme in the background

醫療器材電氣安全法規概述與實務討論研習課程
本課程將針對新舊版本差異及設計注意事項,常見問題等做一全盤性的闡述。
課程概述
EN 60601-1 ,IEC 60601-1 是所有電氣醫療器械的基本安全要求,而最新的版本 EN60601-1(2006)、IEC60601-1(2005),針對風險管理、電擊防護、過熱、防火、機械…等規定,均有大輻度的變更。本課程將針對新舊版本差異及設計注意事項,常見問題等做一全盤性的闡述。
課程大綱
- EN / IEC 60601-1 新版本架構及實施現況
- 新舊版本差異說明
- 常見問題討論
課程對象
專業人員、技術人員。
費用
- 每人新台幣 6,000 元 (包含講義、餐點、證書及5%營業稅)
- DNV 客戶一律九折優惠,同一課程報名三名以上享八五折優惠
- 非 DNV 客戶同一課程報名三名以上者,第三名起九折優惠
時數
1 天,共 6 小時
報名/繳費/退費須知
- 一律採通訊報名不接受現場報名
- 報名完成後會收到付款通知,請於收到付款通知後的5天內完成繳費,未完成繳費者恕難保留名額
- 因場地空間限制名額有限,額滿即截止報名
- 完成報名繳費後因個人因素無法上課,可於開課前致電《DNV》培訓專線 : 02-8253 8215,完成轉讓程序,將名額轉讓給他人使用
- 退費規定︰開課前2周前,100%全額退費;開課前3-14天,退還課程50%費用;開課前3天或已開課,恕無法退費
上課須知
- 課程當天請於08:40開始報到
- 學員應全程參與本課程並通過課後測驗,才能獲得證書,缺一不可。若缺課超過1小時,或未能通過課後測驗者,僅發給參加證明
- 課後測驗採線上方式,請自備可上網的手機、筆電或平板電腦
線上報名, 請按這裡.
若有任何疑問來信請寄:Ivy.Yang@dnv.com 來電請打: 02-8253 8215 楊小姐